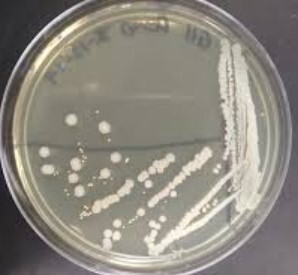
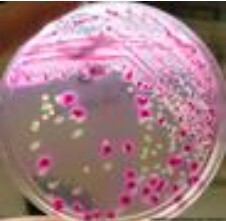

Indophenol oxidase (oxidase) is part of……….
A) the aerobic electron transport chain
B) the anaerobic electron transport chain
C) fermentation
D) hydrogen peroxide breakdown
A) the aerobic electron transport chain
If the field diameter is 6 mm at the 3X objective, what is the field size at the 40X objective?
A) 0.045 mm
B) 4.5 mm
C) 0.45 mm
D) 45 mm
C) 0.45 mm
If you did a catalase test from the bacteria on this blood plate and it bubbled, which species is Staphylococcus?
A) The blue species
B) Both species
C) Cannot tell
D) The cream species

C) Cannot tell
The blood plate can give a false positive result. All staph species are cat +, but not all cat + are staphs, so even if the plate were not a problem, you could not say whether or not these were Staphs without getting more info.
Which of these is the correct equation for the catalase test?
A) hydrogen peroxide —–> carbon dioxide and water
B) 2 H2O2 ——> 2 H2O + 2 O2
C) 2 H2O2 ——> 2 H2O + O2
D) H2O2 ——> 2 H2O + 2 O2
C) 2 H2O2 ——> 2 H2O + O2
Which plate should you NOT use for a catalase test?
A) chocolate plate
B) MacConkeys plate
C) T soy plate
D) blood plate
D) blood plate
How many species have been isolated on this plate?
A) 1
B) 4
C) 3
D) 2
D) 2
How many times do you add bacterial culture to a Petri dish when performing a streak isolation?
A) 4
B) 3
C) 2
D) 1
D) 1
Choose the letter from the medium in the figure that shows a facultative anaerobe growth pattern.
A) D
B) B
C) C
D) E
E) A

D) E
If you had to make a dichotomous key to separate out these three species of bacteria, which of the following would be an appropriate first question?
A) Is it peritrichous?
B) Is it acid fast?
C) Does it have endospores?
D) Does it have inclusion bodies?

C) Does it have endospores?
If an organism is oxidase positive it cannot be a / an…..
A) obligate aerobe
B) obligate anaerobe
C) facultative anaerobe
B) obligate anaerobe
If you had to make a dichotomous key to separate out these three species of bacteria, which of the following would NOT be an appropriate first question?
A) Does it have endospores?
B) Does it have flagella?
C) Does it have a capsule?
D) Does it have hyphae and nucleated cells?

C) Does it have a capsule?
Choose the letter from the medium in the figure that shows an obligate aerobe growth pattern.
A) C
B) E
C) A
D) D
E) B

A) C
Fill in the blank for the missing molecule below in the catalase enzyme-mediated reaction.
2 ________ —————-> 2H2O + O2
H2O2
A positive reaction for catalase appears as…….
A) a bright pink
B) no bubbles
C) purple spots
D) bubbles
D) bubbles
If an organism is oxidase negative it is an anaerobe.
A) Cannot tell
B) True
C) False
A) Cannot tell
Reason: indophenol oxidase is pretty rare and most species are ox-, no matter what oxygen utilization category they are in.
If you were interested in doing Gram stains to determine the shapes of the two species on this plate, are the colonies isolated enough?
A) Yes, they are isolated enough.
B) No, they are not isolated enough.
A) Yes, they are isolated enough.
If an organism is catalase positive it cannot be a / an…..
A) obligate anaerobe
B) facultative anaerobe
C) obligate aerobe
A) obligate anaerobe
Which of these is a negative oxidase result?

A
The scale bar shown is 10 um in length. What is the length of of a single typical bacillus cell shown?
A) 2 micrometers
B) 2 millimeters
C) 0.5 um
D) 0.5 mm

A) 2 micrometers
Reason: 10um/5 cells
What is the goal of the streak isolation technique?
A) To slowly thin out the bacteria to get isolated colonies.
B) To mix the bacteria together.
C) To stab the bacteria underneath the surface of the agar.
D) To get as much bacteria on the plate as possible.
A) To slowly thin out the bacteria to get isolated colonies.


